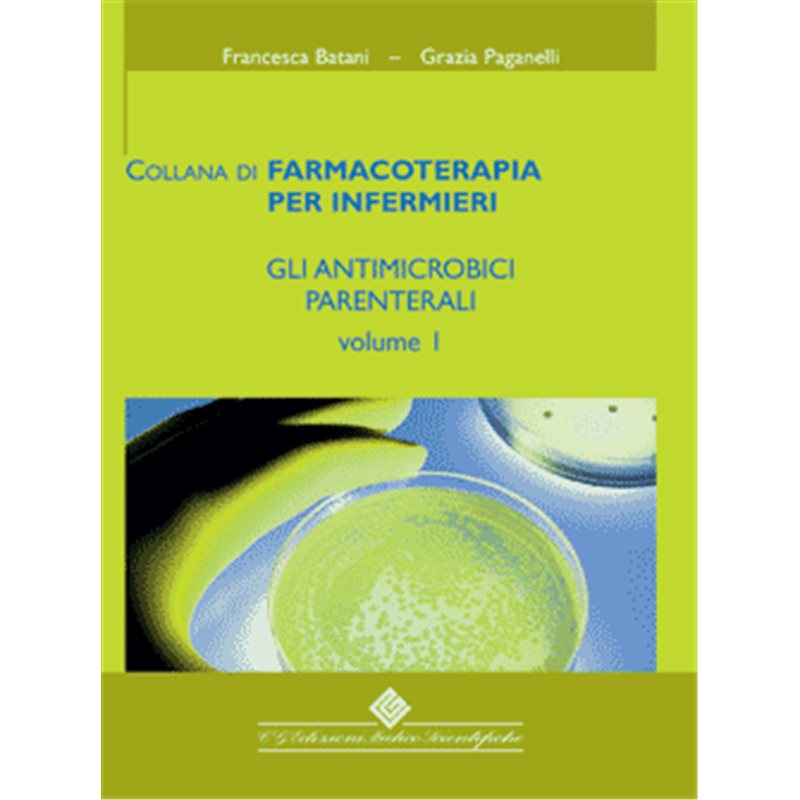

Descrizione
Considerato che in campo sanitario si trovano prontuari di tipo farmaceutico, medico, ospedaliero e non, prontuari ampiamente commentati e ragionati ma nessuno di questi contiene informazioni eo nozioni di interesse prettamente infermieristico, abbiamo dato vita a questa collanamanuale di farmacoterapia per infermieri. La novità data da questa collanamanuale è il MONITORAGGIO INFERMIERISTICO e la COLLABORAZIONE TERAPEUTICA con il paziente. Dopo aver estrapolato tutti i principi attivi, per ciascuno sono state individuate le specialità che l’asl di Cesena ha tenuto sia in un passato recente che al momento attuale. Quindi le autrici hanno confrontato le schede tecniche delle diverse specialità con lo stesso principio attivo, facendo attenzione a segnalare le differenze. Laddove sono state trovate delle diversità queste sono state valutate.

Recensioni
Ancora non ci sono recensioni.